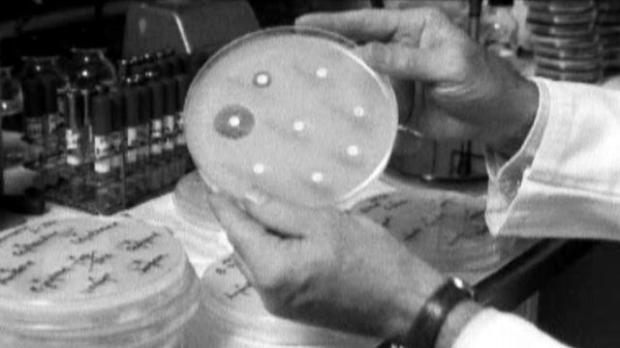
cubs

Long Time Coming
In case you haven’t heard the news, the Chicago Cubs just won the World Series for the 1st time since Teddy Roosevelt was President. In the sports world this is considered a pretty big deal. A lot has happened in the world since October of 1908, and we thought it was a good time to take a look at what we’ve gained in the last 108 years…
If that had not happened we’d never have this song.

The 19th Amendment was passed in 1920. In news that should surprise no one some people still have a problem with this.
Sorry, gluten allergic people (actually, we’re not sorry. WE LOVE BREAD!)

Which is even more important because of how much we love bread.

Without it this website would have a LOT less content.
Without it this website would have a LOT less content.

Without it this website would have a LOT more content.

At this year’s office Christmas party, when you get a copy of someone’s bare butt, you can thank Chester Floyd Carlson and his 1938 invention.

Because screw fiscal responsibility!

Invented for scientific advancement, used by the 1st men on the moon, now a cat torture device.

Pro: It opened us to instantaneous worldwide communication.
Con: It allowed the proliferation of overly sardonic listicles like this.
In closing, I would like to leave you with some Will Ferrell doing Harry Caray because that makes everything better.

Reblogged this on The Adventures of Fort Gaskin-Burr.
LikeLike
This is good. Very good. You write like a friend of mine named Fake_Buck. (It’s an alias, or else he is the only man in history whose middle name is _ ).
Normally when a person of my prominence just shows up and compliments someone, he wants something. I don’t want anything. However, I would like to mention another series of events encapsulated in the period between Chicago Cubs championships. They may be summed up in one word: Titanic.
The R.M.S. Titanic, to be precise. It was an unsinkable ship, a passenger-carrying ocean liner of monstrous size. Construction began in 1909 (well after 1908, obviously), it was launched in 1911, and it sank in 1912, even though it was unsinkable. Its wreckage was not found until 1985, which was the 114th season of the Chicago Cubs franchise, the 110th in the National League and the 70th at Wrigley Field. The Cubs finished fourth in the National League East in 1985, with a record of 77–84.
If I think of any other noteworthy events to round out your tale, I will be happy to send them along, at no charge.
Sincerely,
Mencken
LikeLiked by 1 person
I guess you found me. Hope you are well, sir.
LikeLike
Reblogged this on charmcitysportsguy and commented:
Wrote this for another site I contribute to and I thought it should be here as well.
LikeLike